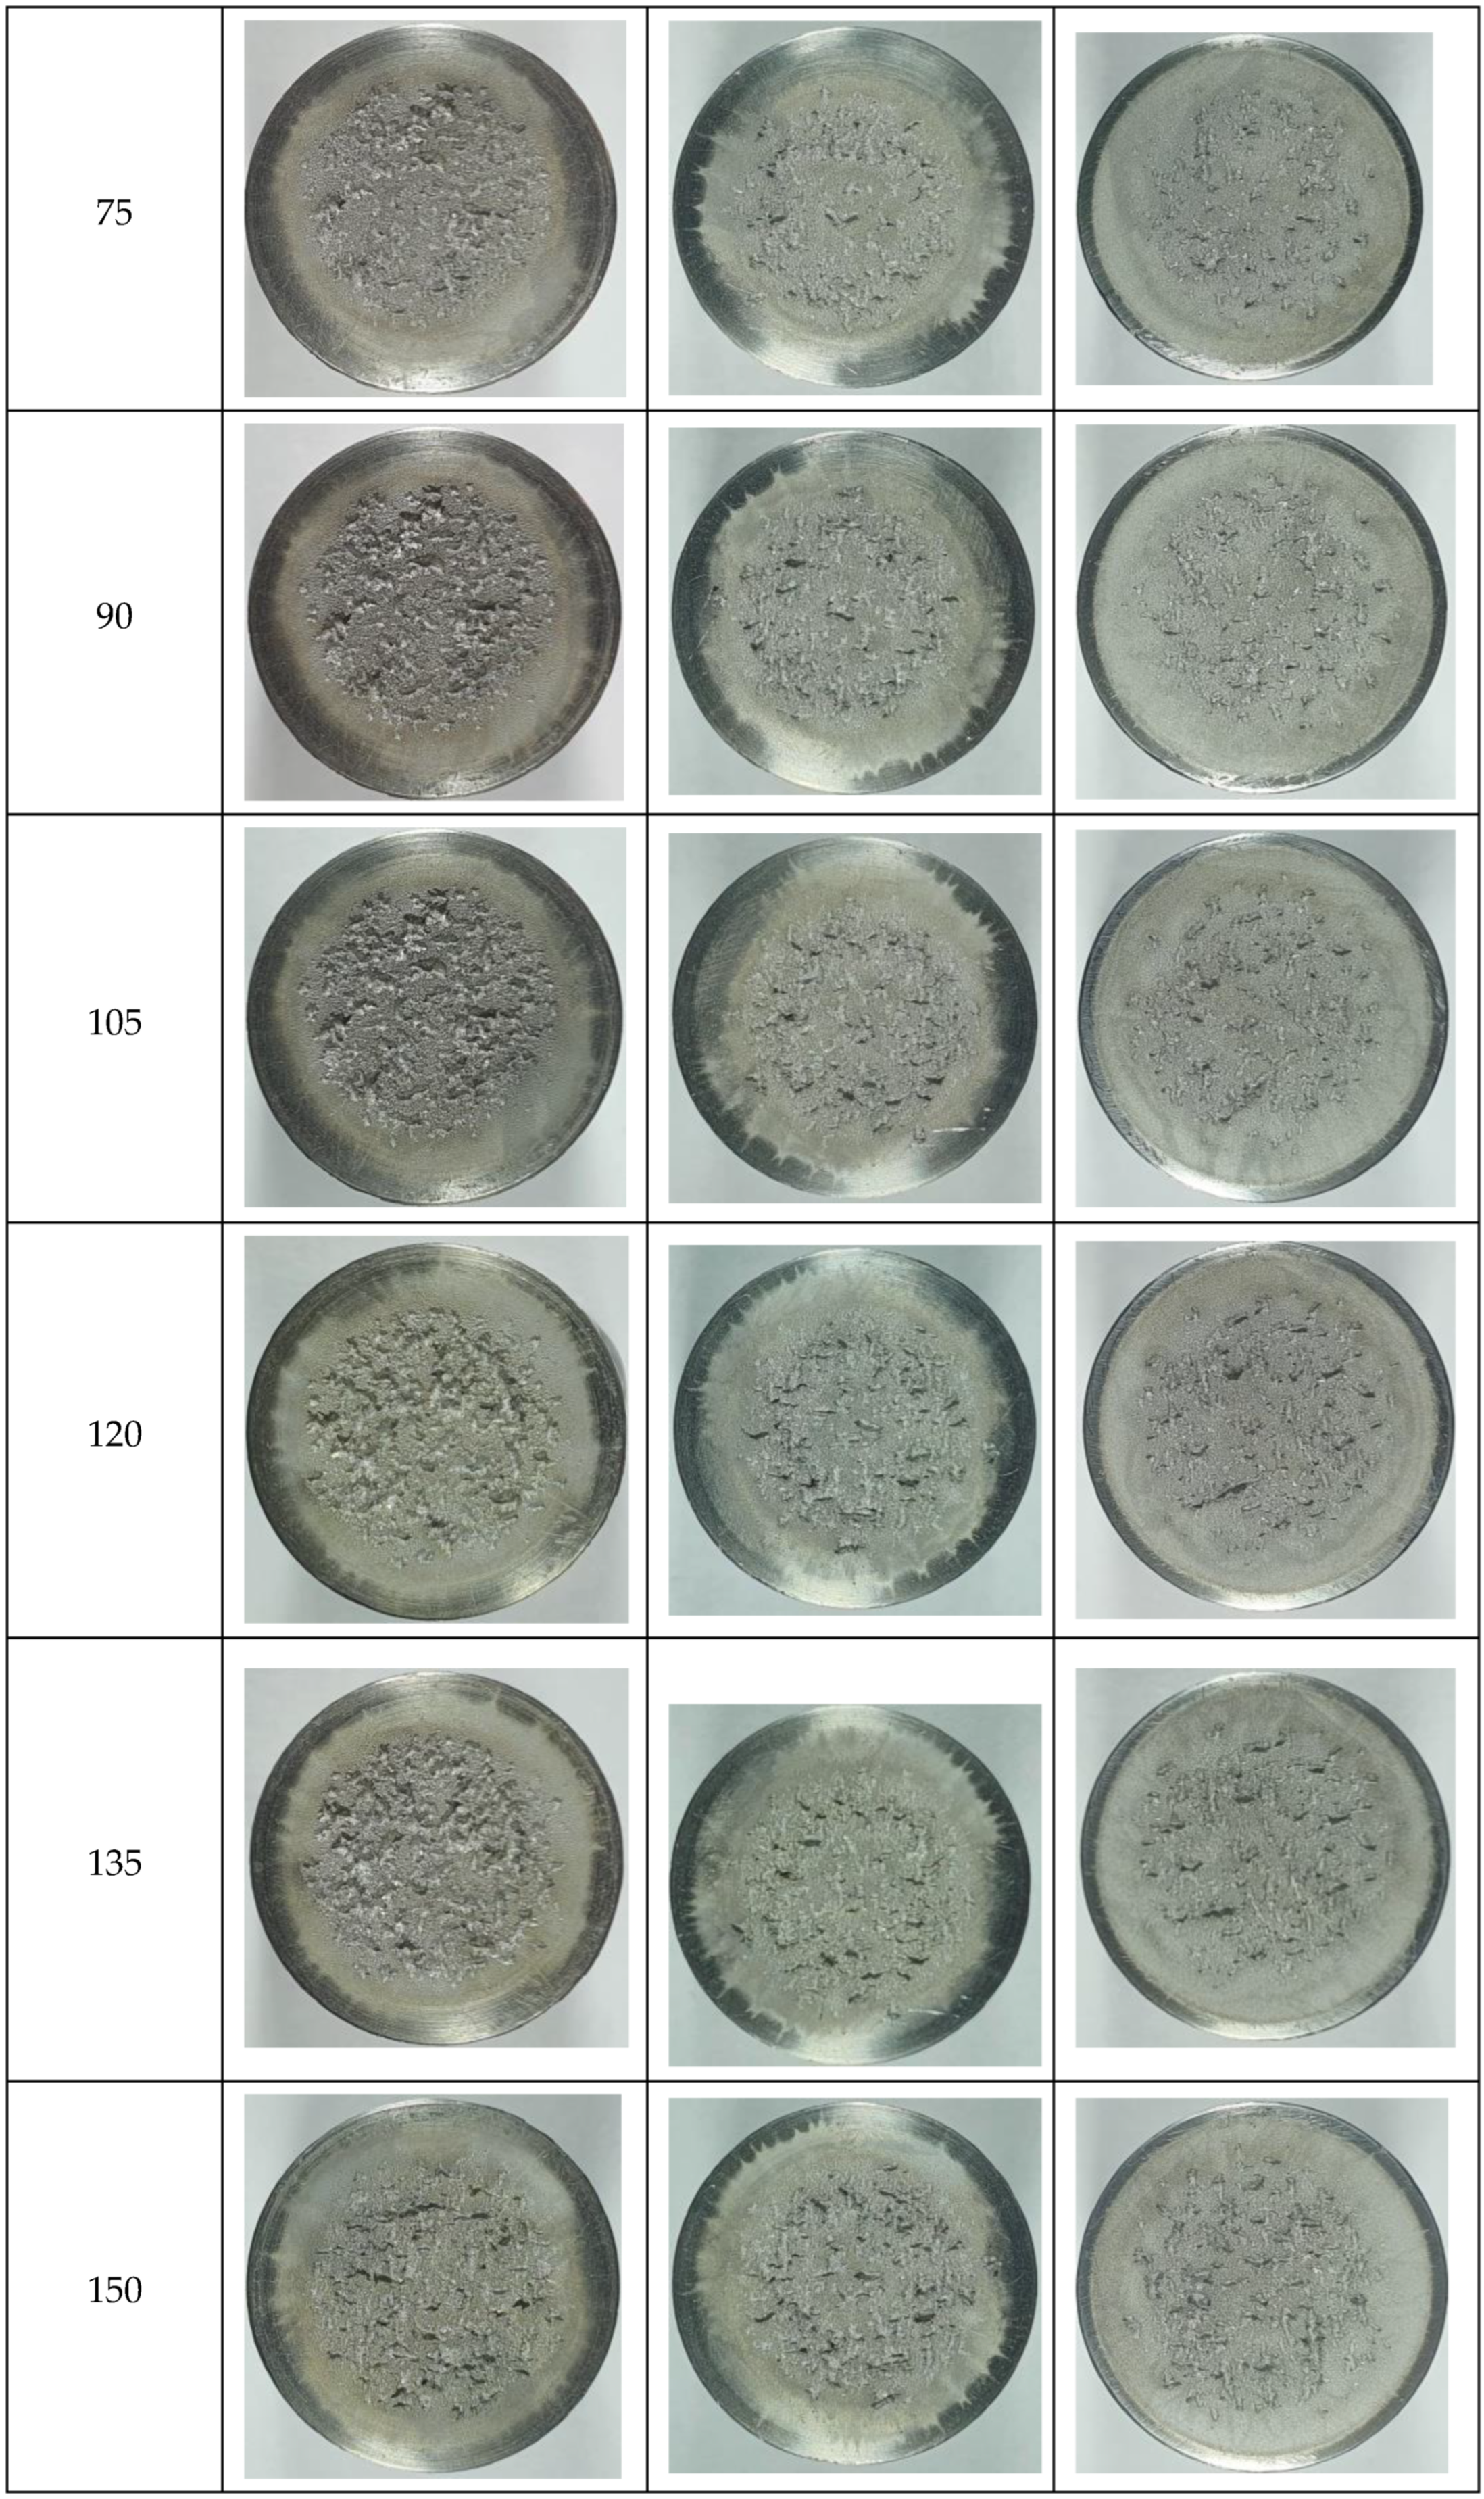
Materials 16 02563 g009b Materials 16 02563 g009b

Cavitation Erosion Characteristics of the EN AW-6082 Aluminum Alloy by TIG Surface Remelting
Abstract
1. Introduction
2. Experimental Procedure
- base metal: Al-6082 alloy;
- welding equipment: MAGIC WAVE 300 (Fronius);
- alternating current frequency: 70 Hz;
- nature of current: alternating current;
- balance: 60/40;
- shielding gas: Ar 100%;
- electrode type: EWLa 15;
- electrode diameter: 3.2 mm;
- gas flow: 10 L/min;
- tilt of the gun: 90 degrees.
- Regime 1:
- i.
- Welding current: Is = 100 A;
- ii.
- Electric arc voltage: Ua = 11 V (RMS = Root Mean Square);
- iii.
- Arc length: 2 mm;
- iv.
- Welding speed: vs. = 10 cm/min;
- v.
- Linear energy: El = 6600 J/cm.
- Regime 2:
- i.
- Welding current: Is = 150 A;
- ii.
- Electric arc voltage: Ua = 12.1 V (RMS);
- iii.
- Arc length: 2 mm;
- iv.
- Welding speed: vs. = 10 cm/min;
- v.
- Linear energy: El = 10,890 J/cm.
- Regime 3:
- i.
- Welding current: Is = 200 A;
- ii.
- Electric arc voltage: Ua = 13.2 V (RMS);
- iii.
- Arc length: 2 mm;
- iv.
- Welding speed: vs. = 10 cm/min;
- v.
- Linear energy: El = 15,840 J/cm.
- vibration amplitude, 20,000 ± 1% Hz;
- vibration amplitude, 50 µm;
- power of the electronic ultrasound generator, 500 W;
- working environment, potable water having a temperature of 22 ± 1 °C.
3. Results and Discussion
3.1. Cavitation Erosion Curves
- TIG remelting of the considered alloy surface at the currents Is = 100 A, 150 A, and 200 A caused an increase in the cavitation erosion resistance, Rcav, from 1.5 times to 5 times (where Rcav. = 1/MDER, t = 165), compared to the conventional heat treatment specific for this material;
- the use of welding currents of 200 A provided the lowest values of the MDE and MDER;
- during the stabilization period, until the end of the test duration (165 min), the erosion rates of the remelted TIG surfaces acquired values of approx. 0.10–0.32 µm/min, and those specific to the age hardening heat treatment were approx. 0.50 µm/min.
3.2. Macro- and Micrographic Examinations
3.2.1. Macrographs of the Surfaces Tested for Cavitation
3.2.2. Micrograph of the TIG Remelted Layer
3.2.3. Topography of Surfaces Eroded by Cavitation
4. Conclusions
Author Contributions
Funding
Institutional Review Board Statement
Informed Consent Statement
Data Availability Statement
Acknowledgments
Conflicts of Interest
References
- Pola, A.; Montesano, L.; Tocci, M.; Marina La Vecchia, G. Influence of Ultrasound Treatment on Cavitation Erosion Resistance of AlSi7 Alloy. Materials 2017, 10, 256. [Google Scholar] [CrossRef] [PubMed]
- Tomlinson, W.J.; Matthews, S.J. Cavitation erosion of aluminium alloys. J. Mater. Sci. 1994, 29, 1101–1108. [Google Scholar] [CrossRef]
- Dybowski, B.; Szala, M.; Kiełbus, A.; Hejwowski, T. Microstructural phenomena occurring during early stages of cavitation erosion of Al-Si aluminium casting alloys. Solid State Phenom. 2015, 227, 255–258. [Google Scholar] [CrossRef]
- Pola, A.; Montesano, L.; Sinagra, C.; Gelfi, M.; La Vecchia, G.M. Effect of globular microstructure on cavitation erosion resistance of aluminium alloys. Solid State Phenom. 2016, 256, 51–57. [Google Scholar] [CrossRef]
- Chen, H.; Li, J.; Chen, D.; Wang, J. Damages on steel surface at the incubation stage of the vibration cavitation erosion in water. Wear 2008, 265, 692–698. [Google Scholar]
- Gottardi, G.; Tocci, M.; Montesano, L.; Pola, A. Cavitation erosion behaviour of an innovative aluminium alloy for Hybrid Aluminium Forging. Wear 2018, 394–395, 1–10. [Google Scholar] [CrossRef]
- Mitelea, I.; Bordeasu, I.; Cosma (Alexa), D.; Utu, I.D.; Craciunescu, C.M. Microstructure and Cavitation Damage Characteristics of GX40CrNiSi25-20 Cast Stainless Steel by TIG. Materials 2023, 16, 1423. [Google Scholar] [CrossRef] [PubMed]
- Mitelea, I.; Bordeasu, I.; Frant, F.; Utu, I.D. Effect of heat treatment on corrosion and ultrasonic cavitation erosion resistance of AlSi10MnMg alloy. Mater. Test. 2020, 62, 921–926. [Google Scholar]
- Tong, Z.; Jiao, J.; Zhou, W.; Yang, Y.; Chen, L.; Liu, H.; Sun, Y.; Ren, X. Improvement in cavitation erosion resistance of AA5083 aluminium alloy by laser shock processing. Surf. Coat. Technol. 2019, 377, 124799. [Google Scholar] [CrossRef]
- Li, H.; Cui ZLi, Z.; Zhu, S.; Yang, X. Effect of gas nitriding treatment on cavitation erosion behavior of commercially pure Ti and Ti-6Al-4V alloy. Surf. Coat. Technol. 2013, 22, 29–36. [Google Scholar] [CrossRef]
- Kwok, C.T.; Man, H.C.; Cheng, F.T.; Lo, K.H. Developments in laser-based surface engineering processes: With particular reference to protection against cavitation erosion. Surf. Coat. Technol. 2016, 291, 189–204. [Google Scholar] [CrossRef]
- Zhang, S.; Wu, S.; Cui, W.; He, S.; Zhang, C.; Guan, M. Cavitation Erosion Properties of Ni-Based RE Alloy Coating on Monel Alloy by Laser Cladding; Northwest Institute for Nonferrous Metal Research: Xi’an, China, 2018. [Google Scholar]
- Man, H.C.; Kwok, C.T.; Yue, T.M. Cavitation erosion and corrosion behaviour of laser surface alloyed MMC of SiC and Si3N4 on Al alloy AA6061. Surf. Coat. Technol. 2000, 132, 11–20. [Google Scholar] [CrossRef]
- Grewal, H.S.; Arora, H.S.; Singh, H.; Agrawal, A. Surface modification of hydroturbine steel using friction stir processing. Appl. Surf. Sci. 2013, 268, 547–555. [Google Scholar] [CrossRef]
- Selvam, K.; Mandal, P.; Grewal, H.S.; Arora, H.S. Ultrasonic cavitation erosion-corrosion behavior of friction stir processed stainless steel. Ultrason. Sonochem. 2018, 44, 331–339. [Google Scholar] [CrossRef] [PubMed]
- Lathabai, S.; Ottmüller, M.; Fernandez, I. Solid particle erosion behaviour of thermal sprayed ceramic, metallic and polymer coatings. Wear 1998, 221, 93–108. [Google Scholar] [CrossRef]
- Wood, R.J.K.; Mellor, B.G.; Binfield, M.L. Sand erosion performance of detonation gun applied tungsten carbide/cobalt-chromium coatings. Wear 1997, 211, 70–83. [Google Scholar] [CrossRef]
- Mrówka-Nowotnik, G.; Sieniawski, J. Influence of heat treatment on the micrustructure and mechanical properties of 6005 and 6082 aluminium alloys. J. Mater. Process. Technol. 2005, 162–163, 367–372. [Google Scholar] [CrossRef]
- ASTM G 32 Standard; Standard Test Method for Cavitation Erosion Using Vibratory Apparatus. ASTM International: West Conshohocken, PA, USA, 2016.
- Bordeaşu, I.; Patrascoiu, C.; Badarau, R.; Sucitu, L.; Popoviciu, M.; Balasoiu, V. New Contributions in Cavitation Erosion Curves Modeling; FME Transactions Faculty of Mechanical Engineering, New Series, Nr.1/2006; University of Belgrade: Belgrade, Serbia, 2006; Volume 34, pp. 39–44. ISSN 1451-2092. [Google Scholar]
- Bordeasu, I. Eroziunea Cavitationala a Materialelor; Editura Politehnica: Timisoara, Romania, 2006. [Google Scholar]

Disclaimer/Publisher’s Note: The statements, opinions and data contained in all publications are solely those of the individual author(s) and contributor(s) and not of MDPI and/or the editor(s). MDPI and/or the editor(s) disclaim responsibility for any injury to people or property resulting from any ideas, methods, instructions or products referred to in the content. |
© 2023 by the authors. Licensee MDPI, Basel, Switzerland. This article is an open access article distributed under the terms and conditions of the Creative Commons Attribution (CC BY) license (https://creativecommons.org/licenses/by/4.0/).
Share and Cite
Mitelea, I.; Bordeașu, I.; Frant, F.; Uțu, I.-D.; Crăciunescu, C.M.; Ghera, C. Cavitation Erosion Characteristics of the EN AW-6082 Aluminum Alloy by TIG Surface Remelting. Materials 2023, 16, 2563. https://doi.org/10.3390/ma16072563
Mitelea I, Bordeașu I, Frant F, Uțu I-D, Crăciunescu CM, Ghera C. Cavitation Erosion Characteristics of the EN AW-6082 Aluminum Alloy by TIG Surface Remelting. Materials. 2023; 16(7):2563. https://doi.org/10.3390/ma16072563
Chicago/Turabian StyleMitelea, Ion, Ilare Bordeașu, Florin Frant, Ion-Dragoș Uțu, Corneliu Marius Crăciunescu, and Cristian Ghera. 2023. "Cavitation Erosion Characteristics of the EN AW-6082 Aluminum Alloy by TIG Surface Remelting" Materials 16, no. 7: 2563. https://doi.org/10.3390/ma16072563
APA StyleMitelea, I., Bordeașu, I., Frant, F., Uțu, I.-D., Crăciunescu, C. M., & Ghera, C. (2023). Cavitation Erosion Characteristics of the EN AW-6082 Aluminum Alloy by TIG Surface Remelting. Materials, 16(7), 2563. https://doi.org/10.3390/ma16072563

